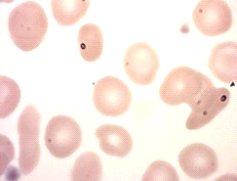

Haemoglobin 6.5 g/dl (
11 to 15 )
White
Blood Cells 11.4 10^9/l (
4 to 11 )
Platelets 351
10^9/l ( 150 to 400 )
Red
Blood Cells 2.49
10^12/l( 3.8 to 4.8 )
Haematocrit 0.191 ratio (
0.36 to 0.46 )
Mean
Cell Volume 76.7
fl ( 80 to 100 )
Mean
Cell Haemoglobin 26.1 pg ( 27 to 32 )
Mean
Cell Haemoglobin Con 34.0 g/dl ( 32 to 36 )
Neutrophils 7.5
10^9/l ( 2 to 7.5 )
Lymphocytes 2.4
10^9/l (
1.5 to 4 )
Monocytes 1.1
10^9/l ( 0.2 to 1 )
Eosinophils 0.3
10^9/l ( 0.02 to 0.5 )
Basophils 0.0
10^9/l ( 0 to 0.1 )
Reticulocyte
count 153.5 10^9/l (
50 to 100 )
Sickle
cells ++; some target cells, occasional howell-jolly bodies. neutrophils with
toxic granulation.
Referred
to consultant haematologist
|
Biochemistry:
Sodium
139 mmol/L
( 133 to 146 )
Potassium 4.4 mmol/L
( 3.5 to 5.3 )
Creatinine 50
umol/L ( 49 to 90 )
GFR
(estimated) >90 units=*
Total
Protein 62 g/L (
60 to 80 )
Albumin 34
g/L ( 35 to 50 )
Globulin 28
g/L ( 20 to 35 )
Total Bilirubin 43 umol/L (
0 to 22 )
Alk
Phos 55 U/L (
30 to 130 )
ALT 18 U/L ( 0 to 50 )
|
A sickle cell test was found to be positive.
Subsequent HPLC showed only a single peak in the HbS position, and no peak in
the HbA position.
Final
Diagnosis: Patient in Sickle Cell Crisis

No comments:
Post a Comment